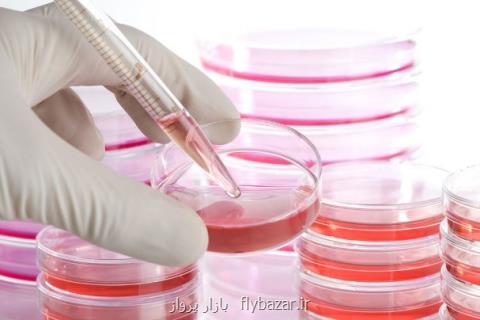

در دانشگاه علوم پزشكی شیراز؛
موفقیت یك شركت دانش بنیان در تولید خون كنترل كننده آزمایشگاه
بازار پرواز: شركتی دانش بنیان در دانشگاه علوم پزشكی شیراز موفق به تولید خون كنترل هماتولوژی شد. از خون كنترل به منظور كنترل و جلوگیری از خطای دستگاه های آزمایشگاهی استفاده می گردد.
بازار پرواز: شركتی دانش بنیان در دانشگاه علوم پزشكی شیراز موفق به تولید خون كنترل هماتولوژی شد. از خون كنترل به منظور كنترل و جلوگیری از خطای دستگاه های آزمایشگاهی استفاده می گردد.
به گزارش بازار پرواز به نقل از دانشگاه علوم پزشكی شیراز، دكتر سید ابوالفضل هاشمی اصل رئیس كمیته پشتیبانی از تولیدات داخلی دانشگاه علوم پزشكی شیراز اظهار داشت: با عنایت به فرمایش مقام معظم رهبری و رسالت كمیته پشتیبانی از تولیدات داخلی و تشویق افراد خلاق و دارای ایده های نوین، دانشگاه علوم پزشكی شیراز از دستاوردها و تولیدات داخلی حمایت می كند. وی اظهار داشت: این حمایت، این دفعه در تولید محلول كنترل خون یك شركت دانش بنیان به ثمر نشست. هاشمی اصل اضافه كرد: این كمیته با حمایت هایی مانند مشاوره و بهره گیری از تجربه و پژوهش اساتید برجسته دانشگاه و همكاری آزمایشگاه های مرجع سلامت، برای به نتیجه رساندن تولید این محصول، تمام تلاش خویش را به كار بست. مدیر امور پشتیبانی و رفاهی دانشگاه علوم پزشكی شیراز با اشاره به اینكه مواد مصرفی موردنیاز برای كنترل و درست بودن دستگاه ها از استان های دیگر و همینطور از خارج كشور وارد می شد، توضیح داد: به كمك این دستاورد جدید با همكاری اساتید دانشگاه از واردات این محصول از خارج استان و خارج از كشور، بی نیاز می شوند. حسین روستا مدیرعامل این شركت دانش بنیان كه شركت تولید كننده خون كنترل در استان فارس و دارای پروانه تولید از ادراه كل دارو و تجهیزات پزشكی كشور است، خاطرنشان كرد: این شركت دارای مجوز كیفی آزمایشگاه مرجع سلامت وزارت بهداشت است و با نظارت مركز رشد بیوتكنولوژی دانشگاه علوم پزشكی شیراز فعالیت می كندن. روستا با اشاره به اینكه این شركت فعالیت خویش را از سال ۱۳۹۱ شروع كرده و بعد از پنج سال پژوهش، به مرحله تولید رسیده است، اضافه كرد: برای كنترل و جلوگیری از خطای دستگاه های آزمایشگاهی(سل كانتر)، به صورت روزانه از روش های مختلفی استفاده می گردد كه خون كنترل كننده همچون این روش هاست. وی به بالا بودن میزان پایداری نمونه ایرانی این محصول نسبت به نمونه های دیگر، بعنوان مزیت محصول این شركت اشاره نمود و افزود: این محصول تنها خون كنترل با پایداری شش ماهه از زمان تولید و دارای بیشترین پایداری نسبت به نمونه های مشابه داخلی و خارجی است؛ هر ویال این محصول ۱۰ روز و سه ویال موجود در یك پكیج، به مدت ۳۰ روز قابل استفاده می باشد. مدیرعامل این شركت دانش بنیان، سازگاری محصول با تمام دستگاه های سل كانتر فول دیف و پارشیال را از دیگر مزایای آن برشمرد. روستا افزود: هم اكنون تولید این محصول ماهانه ۳۰۰ پكیج است كه به صورت مستقیم برای هفت نفر اشتغالزایی داشته است و با همكاری مسئولان، امكان توسعه آن به بیش از هزار پك در ماه هم وجود دارد. وجود سه ویال چهار سی سی نسبت به تمام نمونه های مشابه خارجی و داخلی در بازار با حجم مناسب در هر ویال جهت استفاده ده روزه و بدون دور ریز، كمترین مقدار عددی SD و CV برای پارامترهای محصول و قیمت بسیار مناسب در مقایسه با محصولات مشابه خارجی و داخلی بازار، دیگر مزایایی بود كه مدیرعامل این شركت دانش بنیان به آنها اشاره نمود. او همینطور از بسته بندی مناسب برای حفظ زنجیره سرما، پشتیبانی علمی مناسب، سهولت دسترسی به بخش فنی برای پاسخگویی به پرسش های مصرف كنندگان، راحتی دسترسی به نمونه و تحویل سریع در سراسر كشور بعنوان دیگر مواردی نام برد كه مزیت این محصول را نسبت به دیگر نمونه ها افزایش داده است.
این مطلب را می پسندید؟
(1)
(0)
تازه ترین مطالب مرتبط
نظرات بینندگان در مورد این مطلب